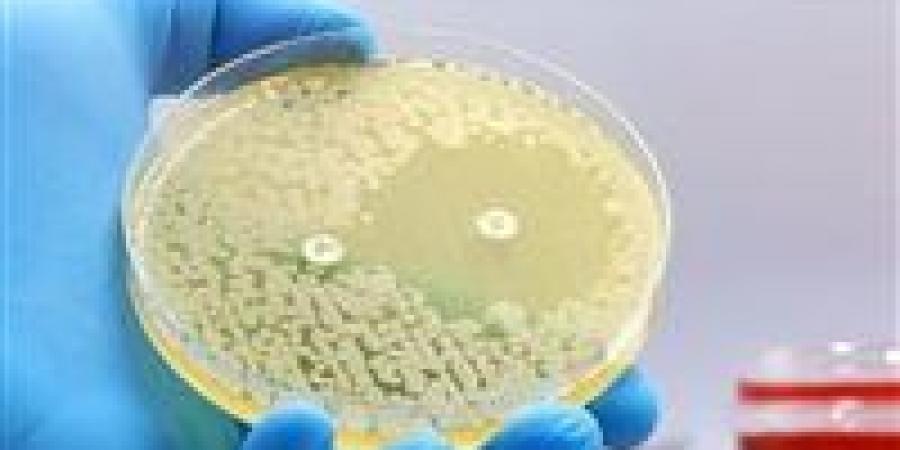
ثورة طبية .. الذكاء الاصطناعي يكتشف مضادات حيوية تهزم أخطر البكتيريا المقاومة

في إنجاز علمي يُعد الأول من نوعه منذ أكثر من 60 عامًا، نجح العلماء في توظيف تقنيات الذكاء الاصطناعي لاكتشاف فئة جديدة من المضادات الحيوية، في خطوة قد تُحدث تحولًا جذريًا في مستقبل الطب ومواجهة الأمراض البكتيرية القاتلة.
سلاح جديد ضد بكتيريا «MRSA» القاتلة
تمكن الباحثون من تطوير مركب مبتكر قادر على القضاء على بكتيريا المكورات العنقودية الذهبية المقاومة للمضادات الحيوية (MRSA)، وهي واحدة من أخطر السلالات البكتيرية التي تتسبب في وفاة آلاف الأشخاص سنويًا حول العالم، بسبب قدرتها العالية على مقاومة العلاجات التقليدية.
نقطة تحول في معركة مقاومة المضادات الحيوية
يمثل هذا الاكتشاف نقلة نوعية في الحرب المستمرة ضد البكتيريا المقاومة، والتي تُعد من أكبر التهديدات الصحية عالميًا. فمع تراجع فعالية العديد من المضادات الحيوية الحالية، يفتح هذا الإنجاز الباب أمام تطوير علاجات أكثر كفاءة وقدرة على التصدي لهذه الكائنات الدقيقة الخطيرة.
كيف ساهم الذكاء الاصطناعي في الاكتشاف؟
اعتمد العلماء على نماذج متقدمة من الذكاء الاصطناعي لتحليل التركيب الكيميائي لملايين الجزيئات، ما مكّنهم من التنبؤ بقدرة بعض المركبات على العمل كمضادات حيوية فعالة، وهو ما كان يستغرق سنوات طويلة باستخدام الطرق التقليدية.
تصريحات علمية: فهم أعمق وآفاق أوسع
قال جيمس كولينز، أستاذ الهندسة الطبية والعلوم في معهد ماساتشوستس للتكنولوجيا، وأحد المشاركين في الدراسة:
"الفكرة الأساسية كانت فهم كيفية توصل النماذج إلى توقع أن جزيئات معينة يمكن أن تكون مضادات حيوية فعالة".
وأضاف أن هذا النهج لا يوفر الوقت والموارد فحسب، بل يمنح العلماء أيضًا رؤية أعمق للآليات الكيميائية التي تحكم عمل هذه المركبات، وهو ما لم يكن متاحًا من قبل بهذا المستوى من الدقة.
المستقبل: بداية عصر جديد في تطوير الأدوية
يُعد هذا الإنجاز مؤشرًا قويًا على دخول الذكاء الاصطناعي مرحلة أكثر تأثيرًا في مجال اكتشاف الأدوية، حيث يمكن أن يُسرّع من وتيرة الابتكار ويُقلل من تكاليف البحث، ما يمهد الطريق أمام تطوير علاجات فعالة لأمراض طالما شكلت تحديًا للعلماء.
بين تهديدات البكتيريا المقاومة وتباطؤ اكتشاف المضادات الحيوية التقليدية، يأتي الذكاء الاصطناعي ليعيد رسم ملامح المعركة، فاتحًا الباب أمام حقبة طبية جديدة قد تنقذ ملايين الأرواح في المستقبل القريب.

0 تعليق